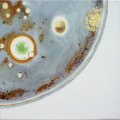
Urszula Cieślik (III rok/GW), Cuda natury II 3, olej na płótnie, 30 x 30 cm, 2020

Pracownia jest otwarta i przyjazna, lecz także wymagająca. Ważnym założeniem naszego programu jest indywidualna praca z każdym studentem i rozwijanie jego osobistych predyspozycji. Studenci na równi z prowadzącym decydują o ewoluującym obliczu pracowni. Dojrzewanie artystyczne to proces rozciągnięty w czasie, ale skuteczny jedynie pod warunkiem, że będzie wypełniony artefaktami, które za każdym razem przesuwają granice osobistych możliwości. Studenci mają prawo do eksperymentów, poszukiwań i pomyłek, zachęca się ich do odważnego, nieskrępowanego myślenia, gotowości do podejmowania ryzyka w imię obrony osobistego postrzegania świata. Chcemy, by studenci byli otwarci na wszelkiego rodzaju bodźce, pochodzące zarówno z otaczającej nas rzeczywistości, jak i z uwolnionej wyobraźni. Korekty powinny zmierzać do znalezienia optymalnego dla predyspozycji studenta rozwiązania problemu malarskiego, w miarę możliwości mają być także wykładem uwzględniającym wybrane aspekty sztuki dawnej, zagadnień sztuki najnowszej oraz problemów warsztatowych i technologicznych. Wiodącym medium jest malarstwo, ale dopuszczalne i oczekiwane jest operowanie środkami wyniesionymi z innych pracowni (np. fotografia, grafika, nowe media). W procesie przygotowania bazujemy na szkicach, zdjęciach, notatkach itp., ale w razie potrzeby studenci mogą także tworzyć klasyczne studium z natury. W związku z tym, że nie ma czegoś takiego jak akademicki warsztat uniwersalny, chcemy, by umiejętności warsztatowe szły w parze z nieskrępowaną wyobraźnią i służyły do realizacji konkretnej indywidualnej wizji, a nie były kształtowane same dla siebie.
-
Prowadzący
Zbigniew Blukacz
- profesor sztuk plastycznych
- profesor
- zblukacz@asp.katowice.pl
- profesor sztuk plastycznych
- profesor
- zblukacz@asp.katowice.pl
Paulina Walczak-Hańderek
- magistra sztuki
- asystentka
- magistra sztuki
- asystentka
-
Prace studentek i studentów 2020-2021
![Monika Gawron (V rok/M)]() Monika Gawron (V rok/M)Boisko przy ul. Andrzeja Wajdy, olej na płótnie, 100 x 150 cm
Monika Gawron (V rok/M)Boisko przy ul. Andrzeja Wajdy, olej na płótnie, 100 x 150 cm![Monika Gawron (V rok/M)]() Monika Gawron (V rok/M)Zespół Szkolno-Przedszkolny nr 2, olej na płótnie, 40 x 60 cm
Monika Gawron (V rok/M)Zespół Szkolno-Przedszkolny nr 2, olej na płótnie, 40 x 60 cm![Monika Gawron (V rok/M)]() Monika Gawron (V rok/M)Widok z domu na pola, olej na płótnie, 80 x 60 cm
Monika Gawron (V rok/M)Widok z domu na pola, olej na płótnie, 80 x 60 cm![Monika Gawron (V rok/M)]() Monika Gawron (V rok/M)Zima na ulicy Zawiszy Czarnego, olej na płótnie, 100 x 150 cm
Monika Gawron (V rok/M)Zima na ulicy Zawiszy Czarnego, olej na płótnie, 100 x 150 cm![Justyna Wolska (V rok/GW)]() Justyna Wolska (V rok/GW)Beztroska, olej na płótnie, 130 x 170 cm
Justyna Wolska (V rok/GW)Beztroska, olej na płótnie, 130 x 170 cm![Justyna Wolska (V rok/GW)]() Justyna Wolska (V rok/GW)(Nie)miejsce, olej na płótnie, 130x170cm
Justyna Wolska (V rok/GW)(Nie)miejsce, olej na płótnie, 130x170cm![Justyna Wolska (V rok/GW)]() Justyna Wolska (V rok/GW)Ruiny, olej na płótnie, 130 x 170 cm
Justyna Wolska (V rok/GW)Ruiny, olej na płótnie, 130 x 170 cm![Justyna Wolska (V rok/GW)]() Justyna Wolska (V rok/GW)(Nie)widzialność, olej na płótnie, 130 x 170 cm
Justyna Wolska (V rok/GW)(Nie)widzialność, olej na płótnie, 130 x 170 cm![Paulina Wojciechowska (V rok/GW)]() Paulina Wojciechowska (V rok/GW)
Paulina Wojciechowska (V rok/GW)![Paulina Wojciechowska (V rok/GW)]() Paulina Wojciechowska (V rok/GW)
Paulina Wojciechowska (V rok/GW)![Paulina Wojciechowska (V rok/GW)]() Paulina Wojciechowska (V rok/GW)
Paulina Wojciechowska (V rok/GW)![Paulina Wojciechowska (V rok/GW)]() Paulina Wojciechowska (V rok/GW)
Paulina Wojciechowska (V rok/GW)![Maja Kielar (V rok/M)]() Maja Kielar (V rok/M)
Maja Kielar (V rok/M)![Marta Zygmunt (V rok/M)]() Marta Zygmunt (V rok/M)
Marta Zygmunt (V rok/M)![Małgorzata Mazur (V rok/M)]() Małgorzata Mazur (V rok/M)
Małgorzata Mazur (V rok/M)![Szymon Poloczek (IV rok/M)]() Szymon Poloczek (IV rok/M)
Szymon Poloczek (IV rok/M)![Szymon Poloczek (IV rok/M)]() Szymon Poloczek (IV rok/M)
Szymon Poloczek (IV rok/M)![Szymon Poloczek (IV rok/M)]() Szymon Poloczek (IV rok/M)
Szymon Poloczek (IV rok/M)![Natalia Szwed (IV rok/GW)]() Natalia Szwed (IV rok/GW)
Natalia Szwed (IV rok/GW)![Natalia Szwed (IV rok/GW)]() Natalia Szwed (IV rok/GW)
Natalia Szwed (IV rok/GW)![Natalia Szwed (IV rok/GW)]() Natalia Szwed (IV rok/GW)
Natalia Szwed (IV rok/GW)![Kalina Brataniec]() Kalina Brataniec
Kalina Brataniec![Kalina Brataniec]() Kalina Brataniec
Kalina Brataniec![Kalina Brataniec]() Kalina Brataniec
Kalina Brataniec![Aleksandra Sznapka]() Aleksandra Sznapka
Aleksandra Sznapka![Aleksandra Sznapka]() Aleksandra Sznapka
Aleksandra Sznapka![Aleksandra Sznapka]() Aleksandra Sznapka
Aleksandra Sznapka![Aleksandra Sznapka]() Aleksandra Sznapka
Aleksandra Sznapka![Aleksandra Sznapka]() Aleksandra Sznapka
Aleksandra Sznapka![Aleksandra Sznapka]() Aleksandra SznapkaAgata TomorowiczAgata Tomorowicz
Aleksandra SznapkaAgata TomorowiczAgata Tomorowicz![Hanna Górecka (III rok/M)]() Hanna Górecka (III rok/M)
Hanna Górecka (III rok/M)![Hanna Górecka (III rok/M)]() Hanna Górecka (III rok/M)
Hanna Górecka (III rok/M)![Hanna Górecka (III rok/M)]() Hanna Górecka (III rok/M)Klaudia Brzezińska (III rok/GW)Ucięto mi powietrze, którym byłam napełniona
Hanna Górecka (III rok/M)Klaudia Brzezińska (III rok/GW)Ucięto mi powietrze, którym byłam napełniona![Klaudia Brzezińska (III rok/GW)]() Klaudia Brzezińska (III rok/GW)Świecę
Klaudia Brzezińska (III rok/GW)Świecę![Klaudia Brzezińska (III rok/GW)]() Klaudia Brzezińska (III rok/GW)Moje gołębie skrzydełka
Klaudia Brzezińska (III rok/GW)Moje gołębie skrzydełka![Klaudia Brzezińska (III rok/GW)]() Klaudia Brzezińska (III rok/GW)Zdarzenie
Klaudia Brzezińska (III rok/GW)Zdarzenie![Marcela Gawęda (III rok/GW)]() Marcela Gawęda (III rok/GW)Dopełnienie II, 180 x 130 cm
Marcela Gawęda (III rok/GW)Dopełnienie II, 180 x 130 cm![Marcela Gawęda (III rok/GW)]() Marcela Gawęda (III rok/GW)Dopełnienie IV, 240 x 60 cm
Marcela Gawęda (III rok/GW)Dopełnienie IV, 240 x 60 cm![Marcela Gawęda (III rok/GW)]() Marcela Gawęda (III rok/GW)Dopełnienie III, 100 x 40 cm
Marcela Gawęda (III rok/GW)Dopełnienie III, 100 x 40 cm![Zbigniew Gurnacz (III rok/M)]() Zbigniew Gurnacz (III rok/M)Pustynia, akwarela na płycie, 80x62cm, 2020
Zbigniew Gurnacz (III rok/M)Pustynia, akwarela na płycie, 80x62cm, 2020![Zbigniew Gurnacz (III rok/M)]() Zbigniew Gurnacz (III rok/M)Agnieszka, akwarela na płycie, 62x80cm,2020
Zbigniew Gurnacz (III rok/M)Agnieszka, akwarela na płycie, 62x80cm,2020![Dawid Szydło (II rok/M)]() Dawid Szydło (II rok/M)Spowiedź, 200 x 140 cm
Dawid Szydło (II rok/M)Spowiedź, 200 x 140 cm![Dawid Szydło (II rok/M)]() Dawid Szydło (II rok/M)Bierzmowanie, 40 x 300 cm
Dawid Szydło (II rok/M)Bierzmowanie, 40 x 300 cm![Dawid Szydło (II rok/M)]() Dawid Szydło (II rok/M)Małżeństwo, 40 x 50 cm
Dawid Szydło (II rok/M)Małżeństwo, 40 x 50 cm![Marcella Mrózek (II rok/GW)]() Marcella Mrózek (II rok/GW)
Marcella Mrózek (II rok/GW)![Noemi Wspaniała (II rok/M)]() Noemi Wspaniała (II rok/M)
Noemi Wspaniała (II rok/M)![Noemi Wspaniała (II rok/M)]() Noemi Wspaniała (II rok/M)
Noemi Wspaniała (II rok/M)![Elżbieta Budziak (II rok/GW)]() Elżbieta Budziak (II rok/GW)
Elżbieta Budziak (II rok/GW)![Elżbieta Budziak (II rok/GW)]() Elżbieta Budziak (II rok/GW)
Elżbieta Budziak (II rok/GW)![Ewa Sznober (II rok/GW)]() Ewa Sznober (II rok/GW)
Ewa Sznober (II rok/GW)![Ewa Sznober (II rok/GW)]() Ewa Sznober (II rok/GW)
Ewa Sznober (II rok/GW)![Ewa Sznober (II rok/GW)]() Ewa Sznober (II rok/GW)
Ewa Sznober (II rok/GW)![Barbara Klus (II rok/GW)]() Barbara Klus (II rok/GW)Krojenie kurczaka
Barbara Klus (II rok/GW)Krojenie kurczaka![Barbara Kus (II rok/GW)]() Barbara Kus (II rok/GW)AfrykariumBarbara Kus (II rok/GW)Slajd z
Barbara Kus (II rok/GW)AfrykariumBarbara Kus (II rok/GW)Slajd z
-
Prace studentek i studentów 2019 - 2020
![Bogna Bartkowiak (III rok/GW), Wnętrze II, akryl na płótnie, 80 x 80 cm, 2020]() Bogna Bartkowiak (III rok/GW), Wnętrze II, akryl na płótnie, 80 x 80 cm, 2020
Bogna Bartkowiak (III rok/GW), Wnętrze II, akryl na płótnie, 80 x 80 cm, 2020![Bogna Bartkowiak (III rok/GW), Mikro, tusz, olej na_płótnie, 110 x 100 cm, 2020]() Bogna Bartkowiak (III rok/GW), Mikro, tusz, olej na_płótnie, 110 x 100 cm, 2020
Bogna Bartkowiak (III rok/GW), Mikro, tusz, olej na_płótnie, 110 x 100 cm, 2020![Bogna Bartkowiak (III rok/GW), Mikro (fragment), tusz, olej na_płótnie, 110 x 100 cm, 2020]() Bogna Bartkowiak (III rok/GW), Mikro (fragment), tusz, olej na_płótnie, 110 x 100 cm, 2020
Bogna Bartkowiak (III rok/GW), Mikro (fragment), tusz, olej na_płótnie, 110 x 100 cm, 2020![Bogna Bartkowiak (III rok/GW), Struktura III, technika mieszana na płótnie, 30 x 30 cm, 2020]() Bogna Bartkowiak (III rok/GW), Struktura III, technika mieszana na płótnie, 30 x 30 cm, 2020Maria Bąk (II rok/GW), Powrót 4, olej na płótnie, 100 x 100 cm, 2020Maria Bąk (II rok/GW), Powrót 3, olej na płótnie, 120 x 100 cm, 2020Maria Bąk (II rok/GW), Zmęczenie 2, olej na płótnie, 180 x 100 cm, 2020Klaudia Brzezińska (II rok/GW), Wdarł się, olej na papierze, 150 x 109, 2019
Bogna Bartkowiak (III rok/GW), Struktura III, technika mieszana na płótnie, 30 x 30 cm, 2020Maria Bąk (II rok/GW), Powrót 4, olej na płótnie, 100 x 100 cm, 2020Maria Bąk (II rok/GW), Powrót 3, olej na płótnie, 120 x 100 cm, 2020Maria Bąk (II rok/GW), Zmęczenie 2, olej na płótnie, 180 x 100 cm, 2020Klaudia Brzezińska (II rok/GW), Wdarł się, olej na papierze, 150 x 109, 2019![Klaudia Brzezińska (II rok/GW), Olka, olej_na_papierze, 178 x 150 cm, 2020]() Klaudia Brzezińska (II rok/GW), Olka, olej_na_papierze, 178 x 150 cm, 2020Klaudia Brzezińska (II rok/GW), Zostań moim pieskiem, olej na papierze, 213 x 150, 2020
Klaudia Brzezińska (II rok/GW), Olka, olej_na_papierze, 178 x 150 cm, 2020Klaudia Brzezińska (II rok/GW), Zostań moim pieskiem, olej na papierze, 213 x 150, 2020![Urszula Cieślik (III rok/GW), Cuda natury, olej na płótnie, 70 x 50 cm, 2020]() Urszula Cieślik (III rok/GW), Cuda natury, olej na płótnie, 70 x 50 cm, 2020
Urszula Cieślik (III rok/GW), Cuda natury, olej na płótnie, 70 x 50 cm, 2020![Urszula Cieślik (III rok/GW), Cuda natury II 2, akryl na płótnie, 30 x 30 cm, 2020]() Urszula Cieślik (III rok/GW), Cuda natury II 2, akryl na płótnie, 30 x 30 cm, 2020
Urszula Cieślik (III rok/GW), Cuda natury II 2, akryl na płótnie, 30 x 30 cm, 2020![Urszula Cieślik (III rok/GW), Cuda natury II 3, olej na płótnie, 30 x 30 cm, 2020]() Urszula Cieślik (III rok/GW), Cuda natury II 3, olej na płótnie, 30 x 30 cm, 2020
Urszula Cieślik (III rok/GW), Cuda natury II 3, olej na płótnie, 30 x 30 cm, 2020![Anna Drobczyk (IV rok/GW), Bez Tytułu, 160 x 80 cm, 2019]() Anna Drobczyk (IV rok/GW), Bez Tytułu, 160 x 80 cm, 2019
Anna Drobczyk (IV rok/GW), Bez Tytułu, 160 x 80 cm, 2019![Anna Drobczyk (IV rok/GW), Znudziłam się czekaniem, 150 x 100 cm, 2020]() Anna Drobczyk (IV rok/GW), Znudziłam się czekaniem, 150 x 100 cm, 2020
Anna Drobczyk (IV rok/GW), Znudziłam się czekaniem, 150 x 100 cm, 2020![Marcela Gawęda (II rok/GW) Defekt II, olej na płótnie, 100 x 80 cm, 2020]() Marcela Gawęda (II rok/GW) Defekt II, olej na płótnie, 100 x 80 cm, 2020
Marcela Gawęda (II rok/GW) Defekt II, olej na płótnie, 100 x 80 cm, 2020![Marcela Gawęda (II rok/GW), Defekt III, olej na płótnie, 100 x 65 cm, 2020]() Marcela Gawęda (II rok/GW), Defekt III, olej na płótnie, 100 x 65 cm, 2020
Marcela Gawęda (II rok/GW), Defekt III, olej na płótnie, 100 x 65 cm, 2020![Marcela Gawęda (II rok/GW), Defekt IV, olej na płótnie, 100 x 70 cm, 2020]() Marcela Gawęda (II rok/GW), Defekt IV, olej na płótnie, 100 x 70 cm, 2020
Marcela Gawęda (II rok/GW), Defekt IV, olej na płótnie, 100 x 70 cm, 2020![Monika Gawron (IV rok/M), Bez tytułu, olej na pilśni, 110 x 100 cm, 2019]() Monika Gawron (IV rok/M), Bez tytułu, olej na pilśni, 110 x 100 cm, 2019
Monika Gawron (IV rok/M), Bez tytułu, olej na pilśni, 110 x 100 cm, 2019![Monika Gawron (IV rok/M), Bez tytułu, olej na płótnie, 130 x 80 cm, 2019]() Monika Gawron (IV rok/M), Bez tytułu, olej na płótnie, 130 x 80 cm, 2019
Monika Gawron (IV rok/M), Bez tytułu, olej na płótnie, 130 x 80 cm, 2019![Monika Gawron (IV rok/M), Bez tytułu, olej na płótnie, 100 x 110 cm, 2019]() Monika Gawron (IV rok/M), Bez tytułu, olej na płótnie, 100 x 110 cm, 2019
Monika Gawron (IV rok/M), Bez tytułu, olej na płótnie, 100 x 110 cm, 2019![Hanna Górecka (II rok/M), Cykl kobiecy 2, olej na płótnie, 30 x 25 cm, 2020]() Hanna Górecka (II rok/M), Cykl kobiecy 2, olej na płótnie, 30 x 25 cm, 2020
Hanna Górecka (II rok/M), Cykl kobiecy 2, olej na płótnie, 30 x 25 cm, 2020![Hanna Górecka (II rok/M), Cykl kobiecy 3, olej na płótnie, 30 x 25 cm, 2020]() Hanna Górecka (II rok/M), Cykl kobiecy 3, olej na płótnie, 30 x 25 cm, 2020
Hanna Górecka (II rok/M), Cykl kobiecy 3, olej na płótnie, 30 x 25 cm, 2020![Hanna Górecka (II rok/M), Cykl męski 2a, olej na płótnie, 18 x 13 cm, 2020]() Hanna Górecka (II rok/M), Cykl męski 2a, olej na płótnie, 18 x 13 cm, 2020
Hanna Górecka (II rok/M), Cykl męski 2a, olej na płótnie, 18 x 13 cm, 2020![Janina Janicka-Grabowska (V rok/M), bez tytułu, olej na płótnie, 140 x 180 cm, 2020]() Janina Janicka-Grabowska (V rok/M), bez tytułu, olej na płótnie, 140 x 180 cm, 2020
Janina Janicka-Grabowska (V rok/M), bez tytułu, olej na płótnie, 140 x 180 cm, 2020![Janina Janicka-Grabowska (V rok/M), bez tytułu, olej na płótnie, 90 x 110 cm, 2020]() Janina Janicka-Grabowska (V rok/M), bez tytułu, olej na płótnie, 90 x 110 cm, 2020
Janina Janicka-Grabowska (V rok/M), bez tytułu, olej na płótnie, 90 x 110 cm, 2020![Zbigniew Gurnacz (III rok/M), Wspomnienie 3, akryl na płótnie, 140 × 90 cm, 2020]() Zbigniew Gurnacz (III rok/M), Wspomnienie 3, akryl na płótnie, 140 × 90 cm, 2020
Zbigniew Gurnacz (III rok/M), Wspomnienie 3, akryl na płótnie, 140 × 90 cm, 2020![Zbigniew Gurnacz (III rok/M), Wspomnienie 2, akryl na płótnie, 140 × 90 cm, 2020]() Zbigniew Gurnacz (III rok/M), Wspomnienie 2, akryl na płótnie, 140 × 90 cm, 2020
Zbigniew Gurnacz (III rok/M), Wspomnienie 2, akryl na płótnie, 140 × 90 cm, 2020![Zbigniew Gurnacz (III rok/M), Wspomnienie 1, akryl na płótnie, 140 × 90 cm, 2020]() Zbigniew Gurnacz (III rok/M), Wspomnienie 1, akryl na płótnie, 140 × 90 cm, 2020Maja Kielar (IV rok/M), Bez tytułu, olej na płótnie, 100 x 120 cm, 2019Maja Kielar (IV rok/M), Bez tytułu, olej na płótnie, 120 x 140 cm, 2020Maja Kielar (IV rok/M), Bez tytułu, olej na płótnie, 120 x 140 cm, 2020
Zbigniew Gurnacz (III rok/M), Wspomnienie 1, akryl na płótnie, 140 × 90 cm, 2020Maja Kielar (IV rok/M), Bez tytułu, olej na płótnie, 100 x 120 cm, 2019Maja Kielar (IV rok/M), Bez tytułu, olej na płótnie, 120 x 140 cm, 2020Maja Kielar (IV rok/M), Bez tytułu, olej na płótnie, 120 x 140 cm, 2020![Karol Kobryń (V rok/PG), Bez tytułu, 2019]() Karol Kobryń (V rok/PG), Bez tytułu, 2019
Karol Kobryń (V rok/PG), Bez tytułu, 2019![Karol Kobryń (V rok/PG), Bez tytułu, 2020]() Karol Kobryń (V rok/PG), Bez tytułu, 2020
Karol Kobryń (V rok/PG), Bez tytułu, 2020![Karol Kobryń (V rok/PG), Bez tytułu, 2020]() Karol Kobryń (V rok/PG), Bez tytułu, 2020Kamil Maśnica (III rok/M), Klasztor Lubiąż, olej na płótnie, 100 x 70 cm, 2019Kamil Maśnica (III rok/M), Klasztor Lubiąż, olej na płótnie, 60 x 70 cm, 2019Kamil Maśnica (III rok/M), Portret Moniki, olej na płótnie, 35 x 28 cm, 2020
Karol Kobryń (V rok/PG), Bez tytułu, 2020Kamil Maśnica (III rok/M), Klasztor Lubiąż, olej na płótnie, 100 x 70 cm, 2019Kamil Maśnica (III rok/M), Klasztor Lubiąż, olej na płótnie, 60 x 70 cm, 2019Kamil Maśnica (III rok/M), Portret Moniki, olej na płótnie, 35 x 28 cm, 2020![Małgorzata Mazur (IV rok/M), Las, olej na plotnie, 180 x 130 cm, 2020]() Małgorzata Mazur (IV rok/M), Las, olej na plotnie, 180 x 130 cm, 2020
Małgorzata Mazur (IV rok/M), Las, olej na plotnie, 180 x 130 cm, 2020![Małgorzata Mazur (IV rok/M), Bez tytułu, olej na płótnie, pastele olejne, 150 x 100 cm, 2019]() Małgorzata Mazur (IV rok/M), Bez tytułu, olej na płótnie, pastele olejne, 150 x 100 cm, 2019
Małgorzata Mazur (IV rok/M), Bez tytułu, olej na płótnie, pastele olejne, 150 x 100 cm, 2019![Małgorzata Mazur (IV rok/M), Bez tytułu, olej na płótnie, 60 x 80 cm, 2020]() Małgorzata Mazur (IV rok/M), Bez tytułu, olej na płótnie, 60 x 80 cm, 2020
Małgorzata Mazur (IV rok/M), Bez tytułu, olej na płótnie, 60 x 80 cm, 2020![Julia Nowakowska (V rok/GW), Dżungla 1, olej na płótnie, 90 x 80 cm, 2020]() Julia Nowakowska (V rok/GW), Dżungla 1, olej na płótnie, 90 x 80 cm, 2020
Julia Nowakowska (V rok/GW), Dżungla 1, olej na płótnie, 90 x 80 cm, 2020![Julia Nowakowska (V rok/GW), Dżungla 2, olej na płótnie, 120 x 60 cm_2020]() Julia Nowakowska (V rok/GW), Dżungla 2, olej na płótnie, 120 x 60 cm_2020
Julia Nowakowska (V rok/GW), Dżungla 2, olej na płótnie, 120 x 60 cm_2020![Kamila Ostaszewska (IV rok/M), Destrukcja, technika własna, 80 x 100 cm, 2020]() Kamila Ostaszewska (IV rok/M), Destrukcja, technika własna, 80 x 100 cm, 2020
Kamila Ostaszewska (IV rok/M), Destrukcja, technika własna, 80 x 100 cm, 2020![Kamila Ostaszewska (IV rok/M), Bez tytułu, technika własna, 120 x 100 cm, 2020]() Kamila Ostaszewska (IV rok/M), Bez tytułu, technika własna, 120 x 100 cm, 2020
Kamila Ostaszewska (IV rok/M), Bez tytułu, technika własna, 120 x 100 cm, 2020![Kamila Ostaszewska (IV rok/M), Cztery ściany, tkanina, 450 x 260 cm, 2020]() Kamila Ostaszewska (IV rok/M), Cztery ściany, tkanina, 450 x 260 cm, 2020Kamila Ostaszewska (IV rok/M) Cztery ściany, tkanina, 450 x 260 cm, 2020
Kamila Ostaszewska (IV rok/M), Cztery ściany, tkanina, 450 x 260 cm, 2020Kamila Ostaszewska (IV rok/M) Cztery ściany, tkanina, 450 x 260 cm, 2020
Jeden pokój, czyli cztery ściany mogą być centrum całego świata. Ta praca jest pewnym podsumowaniem osobistych doświadczeń związanych z próbami stworzenia poczucia bezpieczeństwa od zera. Moje wszystkie samodzielne miejsca zamieszkania były tymczasowe. Nie tworzyłam więc tych chodników tak, jak należy - do konkretnej przestrzeni. To kolaż różnych pokoi, które w pewnym momencie życia nazywałam "moimi".
Tkanie chodników było kiedyś częścią pewnego rytuału przejścia. Często oznaczało wielkie zmiany dla młodej kobiety - ślub, przeprowadzka, rozstanie się dotychczasowym życiem. Kobiety wspierały się w złożonym i żmudnym procesie tkackim, jednocześnie przygotowując się do stworzenia domowego ogniska. Chodniki były obowiązkowym elementem wnętrza, przede wszystkim dlatego, że chroniły przed zimnem. Nie tylko dosłowne ocieplały wnętrza, izolując ludzkie stopy, ale wprowadzały również przytulny nastrój w surowych wnętrzach.
Dekoracyjna funkcja chodników jest oczywista. Kobiety przy ich tworzeniu, maksymalnie wykorzystywały dostępne materiały. Większość tkaczek pracując pod presją czasu i odliczając potrzebną ilość metrów, nie przywiązywało dużej uwagi do powstających zestawień kolorystycznych. Niektóre z nich, mając taką możliwość, farbowały fragmenty tkanin by skomponować całość według własnego pomysłu. Jednak zdarzało się, że kolory wyrażały czasami aspekt religijny. Pewne gospodynie posiadały różne zestawy tkanin dekoracyjnych, nie tylko chodników. Zmieniały je wraz z nadchodzącym postem lub innym większym świętem.
Chodniki to wyjątkowy rodzaj pamiętnika. Dosłownie składają się z przedmiotów tekstylnych całej rodzinny. Niektóre wytkane pasy przywołują u domowników emocjonalne wspomnienia, a nawet historie o ludziach do których kiedyś należały wykorzystane ubrania. To pozostałość po człowieku wpisana we wnętrze. Ślady użytkowania są echem jego obecności, wtartym w szlaki poruszania się po przestrzeni.![Kamila Ostaszewska (IV rok/M), Cztery ściany, 260 x 450 cm, 2020]() Kamila Ostaszewska (IV rok/M), Cztery ściany, 260 x 450 cm, 2020
Kamila Ostaszewska (IV rok/M), Cztery ściany, 260 x 450 cm, 2020![Kamila Ostaszewska (IV rok/M), Cztery ściany, (fragment), tkanina, 450 x 260 cm, 2020]() Kamila Ostaszewska (IV rok/M), Cztery ściany, (fragment), tkanina, 450 x 260 cm, 2020
Kamila Ostaszewska (IV rok/M), Cztery ściany, (fragment), tkanina, 450 x 260 cm, 2020![Kamila Ostaszewska (IV rok/M), Cztery ściany (kompozycja 1), tkanina, 2020]() Kamila Ostaszewska (IV rok/M), Cztery ściany (kompozycja 1), tkanina, 2020
Kamila Ostaszewska (IV rok/M), Cztery ściany (kompozycja 1), tkanina, 2020![Julia Pałkowska (III rok/GW), Bez tytułu, olej na płótnie, 200 x 200 cm, 2019]() Julia Pałkowska (III rok/GW), Bez tytułu, olej na płótnie, 200 x 200 cm, 2019
Julia Pałkowska (III rok/GW), Bez tytułu, olej na płótnie, 200 x 200 cm, 2019![Julia Pałkowska (III rok/GW), Bez tytułu, olej na płótnie, 100 x 120 cm, 2020]() Julia Pałkowska (III rok/GW), Bez tytułu, olej na płótnie, 100 x 120 cm, 2020
Julia Pałkowska (III rok/GW), Bez tytułu, olej na płótnie, 100 x 120 cm, 2020![Julia Pałkowska (III rok/GW), Bez tytułu, olej na płótnie, 100 x 120 cm, 2020]() Julia Pałkowska (III rok/GW), Bez tytułu, olej na płótnie, 100 x 120 cm, 2020
Julia Pałkowska (III rok/GW), Bez tytułu, olej na płótnie, 100 x 120 cm, 2020![Szymon Poloczek (III rok/M), Konkurs, olej na płótnie, 100 x 100 cm, 2020]() Szymon Poloczek (III rok/M), Konkurs, olej na płótnie, 100 x 100 cm, 2020
Szymon Poloczek (III rok/M), Konkurs, olej na płótnie, 100 x 100 cm, 2020![Szymon Poloczek (III rok/M) Bez tytułu, olej na płótnie, 100 x 100 cm, 2020]() Szymon Poloczek (III rok/M) Bez tytułu, olej na płótnie, 100 x 100 cm, 2020
Szymon Poloczek (III rok/M) Bez tytułu, olej na płótnie, 100 x 100 cm, 2020![Szymon Poloczek (III rok/M) Bez tytułu, olej na płótnie, 2020]() Szymon Poloczek (III rok/M) Bez tytułu, olej na płótnie, 2020
Szymon Poloczek (III rok/M) Bez tytułu, olej na płótnie, 2020![Szymon Poloczek (III rok/M), Pokój Sonii, olej na płótnie, 150 x 100 cm, 2020]() Szymon Poloczek (III rok/M), Pokój Sonii, olej na płótnie, 150 x 100 cm, 2020
Szymon Poloczek (III rok/M), Pokój Sonii, olej na płótnie, 150 x 100 cm, 2020![Martyna Stefaniak (V rok/M), Bez tytułu, olej na płótnie, 2019]() Martyna Stefaniak (V rok/M), Bez tytułu, olej na płótnie, 2019
Martyna Stefaniak (V rok/M), Bez tytułu, olej na płótnie, 2019![Martyna Stefaniak (V rok/M), Bez tytułu, olej na płótnie, 2020]() Martyna Stefaniak (V rok/M), Bez tytułu, olej na płótnie, 2020
Martyna Stefaniak (V rok/M), Bez tytułu, olej na płótnie, 2020![Natalia Szwed (III rok/GW), Północnica, olej na płótnie, 90 x 90 cm, 2019]() Natalia Szwed (III rok/GW), Północnica, olej na płótnie, 90 x 90 cm, 2019
Natalia Szwed (III rok/GW), Północnica, olej na płótnie, 90 x 90 cm, 2019![Natalia Szwed (III rok/GW), Północnica, olej na płótnie, 100 x 80 cm, 2019]() Natalia Szwed (III rok/GW), Północnica, olej na płótnie, 100 x 80 cm, 2019
Natalia Szwed (III rok/GW), Północnica, olej na płótnie, 100 x 80 cm, 2019![Natalia Szwed (III rok/GW), Ognisko, olej na płótnie, 50 x 70 cm, 2020]() Natalia Szwed (III rok/GW), Ognisko, olej na płótnie, 50 x 70 cm, 2020
Natalia Szwed (III rok/GW), Ognisko, olej na płótnie, 50 x 70 cm, 2020![Natalia Szwed (III rok/GW), Taniec, olej na płótnie, 50 x 70 cm, 2020]() Natalia Szwed (III rok/GW), Taniec, olej na płótnie, 50 x 70 cm, 2020
Natalia Szwed (III rok/GW), Taniec, olej na płótnie, 50 x 70 cm, 2020![Paulina Wojciechowska (IV rok/GW), BMI, akryl na płótnie, 130 x 130 cm, 2019]() Paulina Wojciechowska (IV rok/GW), BMI, akryl na płótnie, 130 x 130 cm, 2019
Paulina Wojciechowska (IV rok/GW), BMI, akryl na płótnie, 130 x 130 cm, 2019![Paulina Wojciechowska (IV rok/GW), Refluks, akryl na płótnie, 125 x 75 cm. 2019]() Paulina Wojciechowska (IV rok/GW), Refluks, akryl na płótnie, 125 x 75 cm. 2019
Paulina Wojciechowska (IV rok/GW), Refluks, akryl na płótnie, 125 x 75 cm. 2019![Paulina Wojciechowska (IV rok/GW), Skin 3, akryl na płótnie, 150 x 100 cm, 2020]() Paulina Wojciechowska (IV rok/GW), Skin 3, akryl na płótnie, 150 x 100 cm, 2020
Paulina Wojciechowska (IV rok/GW), Skin 3, akryl na płótnie, 150 x 100 cm, 2020![Justyna Wolska (IV rok/GW), Mętlik, olej na płótnie, 170 x 130 cm, 2019]() Justyna Wolska (IV rok/GW), Mętlik, olej na płótnie, 170 x 130 cm, 2019
Justyna Wolska (IV rok/GW), Mętlik, olej na płótnie, 170 x 130 cm, 2019![Justyna Wolska (IV rok/GW), Bezgłos, olej na płótnie, 170 x 130 cm, 2020]() Justyna Wolska (IV rok/GW), Bezgłos, olej na płótnie, 170 x 130 cm, 2020
Justyna Wolska (IV rok/GW), Bezgłos, olej na płótnie, 170 x 130 cm, 2020![Justyna Wolska (IV rok/GW), Bez tytułu, olej na płótnie, 170 x 130 cm, 2020]() Justyna Wolska (IV rok/GW), Bez tytułu, olej na płótnie, 170 x 130 cm, 2020
Justyna Wolska (IV rok/GW), Bez tytułu, olej na płótnie, 170 x 130 cm, 2020![Justyna Wolska (IV rok/GW), Bez tytułu, olej na płótnie, 140 x 76 cm, 2020]() Justyna Wolska (IV rok/GW), Bez tytułu, olej na płótnie, 140 x 76 cm, 2020Marta Zygmunt (IV rok/M), Papuga, olej na płótnie, 60 x 80 cm, 2020Marta Zygmunt (IV rok/M), Dziecko, olej na płótnie, 100 x 130 cm, 2020Marta Zygmunt (IV rok/M), Dzieci.natura, olej na płótnie, 100 x 130 cm, 2020
Justyna Wolska (IV rok/GW), Bez tytułu, olej na płótnie, 140 x 76 cm, 2020Marta Zygmunt (IV rok/M), Papuga, olej na płótnie, 60 x 80 cm, 2020Marta Zygmunt (IV rok/M), Dziecko, olej na płótnie, 100 x 130 cm, 2020Marta Zygmunt (IV rok/M), Dzieci.natura, olej na płótnie, 100 x 130 cm, 2020![Kamila Ostaszewska (IV rok/M), Cztery ściany, tkanina, 450 x 260 cm, 2020]() Kamila Ostaszewska (IV rok/M), Cztery ściany, tkanina, 450 x 260 cm, 2020Kamila Ostaszewska (IV rok/M) Cztery ściany, tkanina, 450 x 260 cm, 2020
Kamila Ostaszewska (IV rok/M), Cztery ściany, tkanina, 450 x 260 cm, 2020Kamila Ostaszewska (IV rok/M) Cztery ściany, tkanina, 450 x 260 cm, 2020
Jeden pokój, czyli cztery ściany mogą być centrum całego świata. Ta praca jest pewnym podsumowaniem osobistych doświadczeń związanych z próbami stworzenia poczucia bezpieczeństwa od zera. Moje wszystkie samodzielne miejsca zamieszkania były tymczasowe. Nie tworzyłam więc tych chodników tak, jak należy - do konkretnej przestrzeni. To kolaż różnych pokoi, które w pewnym momencie życia nazywałam "moimi".
Tkanie chodników było kiedyś częścią pewnego rytuału przejścia. Często oznaczało wielkie zmiany dla młodej kobiety - ślub, przeprowadzka, rozstanie się dotychczasowym życiem. Kobiety wspierały się w złożonym i żmudnym procesie tkackim, jednocześnie przygotowując się do stworzenia domowego ogniska. Chodniki były obowiązkowym elementem wnętrza, przede wszystkim dlatego, że chroniły przed zimnem. Nie tylko dosłowne ocieplały wnętrza, izolując ludzkie stopy, ale wprowadzały również przytulny nastrój w surowych wnętrzach.
Dekoracyjna funkcja chodników jest oczywista. Kobiety przy ich tworzeniu, maksymalnie wykorzystywały dostępne materiały. Większość tkaczek pracując pod presją czasu i odliczając potrzebną ilość metrów, nie przywiązywało dużej uwagi do powstających zestawień kolorystycznych. Niektóre z nich, mając taką możliwość, farbowały fragmenty tkanin by skomponować całość według własnego pomysłu. Jednak zdarzało się, że kolory wyrażały czasami aspekt religijny. Pewne gospodynie posiadały różne zestawy tkanin dekoracyjnych, nie tylko chodników. Zmieniały je wraz z nadchodzącym postem lub innym większym świętem.
Chodniki to wyjątkowy rodzaj pamiętnika. Dosłownie składają się z przedmiotów tekstylnych całej rodzinny. Niektóre wytkane pasy przywołują u domowników emocjonalne wspomnienia, a nawet historie o ludziach do których kiedyś należały wykorzystane ubrania. To pozostałość po człowieku wpisana we wnętrze. Ślady użytkowania są echem jego obecności, wtartym w szlaki poruszania się po przestrzeni.Marta Zygmunt (IV rok/M), Dzieci.natura, olej na płótnie, 100 x 130 cm, 2020Slajd z
-
Prace studentek i studentów 2009-2019
![Agnieszka Florczyk, bez tytułu, 180 x 180 cm, olej na płótnie, 2009]() Agnieszka Florczyk, bez tytułu, 180 x 180 cm, olej na płótnie, 2009
Agnieszka Florczyk, bez tytułu, 180 x 180 cm, olej na płótnie, 2009![Agnieszka Florczyk, bez tytułu, olej na płótnie, 2009]() Agnieszka Florczyk, bez tytułu, olej na płótnie, 2009
Agnieszka Florczyk, bez tytułu, olej na płótnie, 2009![Luiza Kolasa, Pół minuty, olej na płótnie, 2010]() Luiza Kolasa, Pół minuty, olej na płótnie, 2010
Luiza Kolasa, Pół minuty, olej na płótnie, 2010![Luiza Kolasa, 10 sekund, olej na płótnie, 2010]() Luiza Kolasa, 10 sekund, olej na płótnie, 2010
Luiza Kolasa, 10 sekund, olej na płótnie, 2010![Luiza Kolasa, Łyk orzeźwienia, olej na płótnie, 2010]() Luiza Kolasa, Łyk orzeźwienia, olej na płótnie, 2010
Luiza Kolasa, Łyk orzeźwienia, olej na płótnie, 2010![Aga Piotrowska, Blizna, olej na płótnie, 50 cm, 2010]() Aga Piotrowska, Blizna, olej na płótnie, 50 cm, 2010
Aga Piotrowska, Blizna, olej na płótnie, 50 cm, 2010![Aga Piotrowska, Tracheotomia, olej na płótnie, 140 x 110 cm, 2012]() Aga Piotrowska, Tracheotomia, olej na płótnie, 140 x 110 cm, 2012
Aga Piotrowska, Tracheotomia, olej na płótnie, 140 x 110 cm, 2012![Marzena Rakoniewska, bez tytułu, olej na płótnie, 140 x 180 cm, 2011]() Marzena Rakoniewska, bez tytułu, olej na płótnie, 140 x 180 cm, 2011
Marzena Rakoniewska, bez tytułu, olej na płótnie, 140 x 180 cm, 2011![Marzena Rakoniewska, bez tytułu, olej na płótnie, 110 x 140 cm, 2011]() Marzena Rakoniewska, bez tytułu, olej na płótnie, 110 x 140 cm, 2011
Marzena Rakoniewska, bez tytułu, olej na płótnie, 110 x 140 cm, 2011![Anna Puszczewicz, Landart 2, olej na płótnie, 70 x 50 cm, 2011]() Anna Puszczewicz, Landart 2, olej na płótnie, 70 x 50 cm, 2011
Anna Puszczewicz, Landart 2, olej na płótnie, 70 x 50 cm, 2011![Anna Puszczewicz, Landart 1, olej na płótnie, 70 x 50 cm, 2011]() Anna Puszczewicz, Landart 1, olej na płótnie, 70 x 50 cm, 2011
Anna Puszczewicz, Landart 1, olej na płótnie, 70 x 50 cm, 2011![Maciej Cholewa, bez tytułu, olej na płótnie, 2013]() Maciej Cholewa, bez tytułu, olej na płótnie, 2013
Maciej Cholewa, bez tytułu, olej na płótnie, 2013![Maciej Cholewa, bez tytułu, olej na płótnie, 2013]() Maciej Cholewa, bez tytułu, olej na płótnie, 2013
Maciej Cholewa, bez tytułu, olej na płótnie, 2013![Monika Panek, bez tytułu, olej na płótnie, 90 x 120 cm, 2013]() Monika Panek, bez tytułu, olej na płótnie, 90 x 120 cm, 2013
Monika Panek, bez tytułu, olej na płótnie, 90 x 120 cm, 2013![Monika Panek, olej na płótnie, 75 x 40 cm, 2013]() Monika Panek, olej na płótnie, 75 x 40 cm, 2013
Monika Panek, olej na płótnie, 75 x 40 cm, 2013![Justyna Szewczyk, Folk II, olej na płótnie, 2013]() Justyna Szewczyk, Folk II, olej na płótnie, 2013
Justyna Szewczyk, Folk II, olej na płótnie, 2013![Justyna Szewczyk, Folk IV, olej na płótnie, 2013]() Justyna Szewczyk, Folk IV, olej na płótnie, 2013
Justyna Szewczyk, Folk IV, olej na płótnie, 2013![Mateusz Hajman, bez tytułu, olej na płótnie, 2014]() Mateusz Hajman, bez tytułu, olej na płótnie, 2014
Mateusz Hajman, bez tytułu, olej na płótnie, 2014![Mateusz Hajman, bez tytułu, olej na płótnie, 2014]() Mateusz Hajman, bez tytułu, olej na płótnie, 2014
Mateusz Hajman, bez tytułu, olej na płótnie, 2014![Łukasz Zaręba, Gorzkie Wody, olej na płótnie, 2014]() Łukasz Zaręba, Gorzkie Wody, olej na płótnie, 2014
Łukasz Zaręba, Gorzkie Wody, olej na płótnie, 2014![Łukasz Zaręba, Dei Gloria Intacta, olej na płótnie, 120 x 90 cm, 2014]() Łukasz Zaręba, Dei Gloria Intacta, olej na płótnie, 120 x 90 cm, 2014
Łukasz Zaręba, Dei Gloria Intacta, olej na płótnie, 120 x 90 cm, 2014![Damian Kater, olej na płótnie, 90 x 205 cm, 2014]() Damian Kater, olej na płótnie, 90 x 205 cm, 2014
Damian Kater, olej na płótnie, 90 x 205 cm, 2014![Damian Kater, olej na płótnie, 110 x 150 cm, 2014]() Damian Kater, olej na płótnie, 110 x 150 cm, 2014
Damian Kater, olej na płótnie, 110 x 150 cm, 2014![Lena Achtelik, bez tytułu, olej na płótnie, 2015]() Lena Achtelik, bez tytułu, olej na płótnie, 2015
Lena Achtelik, bez tytułu, olej na płótnie, 2015![Lena Achtelik, bez tytułu, olej na płótnie, 2015]() Lena Achtelik, bez tytułu, olej na płótnie, 2015
Lena Achtelik, bez tytułu, olej na płótnie, 2015![Nadia Świerczyna, bez tytułu, akryl na płótnie, 2015]() Nadia Świerczyna, bez tytułu, akryl na płótnie, 2015
Nadia Świerczyna, bez tytułu, akryl na płótnie, 2015![Nadia Świerczyna, bez tytułu, akryl na płótnie, 2015]() Nadia Świerczyna, bez tytułu, akryl na płótnie, 2015
Nadia Świerczyna, bez tytułu, akryl na płótnie, 2015![Katarzyna Lembryk, We mgle... , olej na płótnie, 150 x 150 cm, 2016 r.]() Katarzyna Lembryk, We mgle... , olej na płótnie, 150 x 150 cm, 2016 r.
Katarzyna Lembryk, We mgle... , olej na płótnie, 150 x 150 cm, 2016 r.![Katarzyna Lembryk, bez tytułu, olej na płótnie, 2016 r.]() Katarzyna Lembryk, bez tytułu, olej na płótnie, 2016 r.
Katarzyna Lembryk, bez tytułu, olej na płótnie, 2016 r.![Katarzyna Lembryk, bez tytułu, olej na płótnie, 2016 r.]() Katarzyna Lembryk, bez tytułu, olej na płótnie, 2016 r.
Katarzyna Lembryk, bez tytułu, olej na płótnie, 2016 r.![Agnieszka Sośnia, Bezgłosy (front), akryl na desce, 80 x 40 cm, 2017]() Agnieszka Sośnia, Bezgłosy (front), akryl na desce, 80 x 40 cm, 2017
Agnieszka Sośnia, Bezgłosy (front), akryl na desce, 80 x 40 cm, 2017![Agnieszka Sośnia, Bezgłosy (side), akryl na desce, 80 x 40 cm, 2017]() Agnieszka Sośnia, Bezgłosy (side), akryl na desce, 80 x 40 cm, 2017
Agnieszka Sośnia, Bezgłosy (side), akryl na desce, 80 x 40 cm, 2017![Agnieszka Sośnia, Krzak II (front), akryl na desce, 65 x 88 cm, 2017]() Agnieszka Sośnia, Krzak II (front), akryl na desce, 65 x 88 cm, 2017
Agnieszka Sośnia, Krzak II (front), akryl na desce, 65 x 88 cm, 2017![Agnieszka Sośnia, Axis mundi (front), akryl na desce, 50 x 70 cm, 2017]() Agnieszka Sośnia, Axis mundi (front), akryl na desce, 50 x 70 cm, 2017
Agnieszka Sośnia, Axis mundi (front), akryl na desce, 50 x 70 cm, 2017![Agnieszka Sośnia, Axis mundi (side), akryl na desce, 50 x 70 cm, 2017]() Agnieszka Sośnia, Axis mundi (side), akryl na desce, 50 x 70 cm, 2017
Agnieszka Sośnia, Axis mundi (side), akryl na desce, 50 x 70 cm, 2017![Łukasz Koniuszy, Monochrom 3, akryl na desce, 2018]() Łukasz Koniuszy, Monochrom 3, akryl na desce, 2018
Łukasz Koniuszy, Monochrom 3, akryl na desce, 2018![Łukasz Koniuszy, Monochrom 2, akryl na desce, 2018]() Łukasz Koniuszy, Monochrom 2, akryl na desce, 2018
Łukasz Koniuszy, Monochrom 2, akryl na desce, 2018![Piotr Kwiatkowski, Alfa- Omega, olej na płótnie, 2018]() Piotr Kwiatkowski, Alfa- Omega, olej na płótnie, 2018
Piotr Kwiatkowski, Alfa- Omega, olej na płótnie, 2018![Piotr Kwiatkowski, Swoim otwierającym spojrzeniem, olej na płótnie, 2018]() Piotr Kwiatkowski, Swoim otwierającym spojrzeniem, olej na płótnie, 2018
Piotr Kwiatkowski, Swoim otwierającym spojrzeniem, olej na płótnie, 2018![Darya Hancharova, Fotoplastikon osobowości 6, akryl na płótnie, 100 x 120 cm, 2019]() Darya Hancharova, Fotoplastikon osobowości 6, akryl na płótnie, 100 x 120 cm, 2019
Darya Hancharova, Fotoplastikon osobowości 6, akryl na płótnie, 100 x 120 cm, 2019![Darya Hancharova, Fotoplastikon osobowości 5, akryl na płótnie, 170 x 130 cm, 2019]() Darya Hancharova, Fotoplastikon osobowości 5, akryl na płótnie, 170 x 130 cm, 2019
Darya Hancharova, Fotoplastikon osobowości 5, akryl na płótnie, 170 x 130 cm, 2019![Darya Hancharova, Fotoplastikon osobowości 4, akryl na płótnie, 120 x 90 cm, 2019]() Darya Hancharova, Fotoplastikon osobowości 4, akryl na płótnie, 120 x 90 cm, 2019Julia Świtaj, bez tytułu, olej na płótnie, 2019
Darya Hancharova, Fotoplastikon osobowości 4, akryl na płótnie, 120 x 90 cm, 2019Julia Świtaj, bez tytułu, olej na płótnie, 2019![Julia Świtaj, bez tytułu, olej na płótnie, 2019]() Julia Świtaj, bez tytułu, olej na płótnie, 2019Julia Świtaj, bez tytułu, olej na płótnie, 2019Julia Świtaj, bez tytułu, olej na płótnie, 2019Slajd z
Julia Świtaj, bez tytułu, olej na płótnie, 2019Julia Świtaj, bez tytułu, olej na płótnie, 2019Julia Świtaj, bez tytułu, olej na płótnie, 2019Slajd z
-
karta przedmiotu
Malarstwo
poziom studiów: jednolite studia magisterskie
forma studiów: stacjonarne
cykl kształcenia: 2024/2025
Prowadzący: prof. dr hab. Zbigniew Blukacz, mgr Paulina Walczak-Hańderek
Forma zaliczenia: zaliczenie z oceną
Język wykładowy: polskiSkrócona karta przedmiotu
Moduł
moduł kształcenia kierunkowego
obowiązkowy
X
z wyboru
Założenia i cele przedmiotu
Treści programowe poruszają się wokół zjawiska obrazu lub działań około malarskich jako korelacji: wyobraźni, obserwacji, analizy, syntezy, dekonstrukcji, konstrukcji, duchowości i kreacji.
W semestrze dziewiątym osoba studencka musi określić obszar tematu swojej pracy dyplomowej(specjalizacja dodatkowa), jeśli będzie ona realizowana w naszej pracowni. Dzięki wypracowanym wcześniej metodom osoba studencka poszukuje odpowiedniej formy dla tematu dyplomu dodatkowego poprzez pracę nad projektami. Może kontynuować poruszane wcześniej problemy artystyczne pod warunkiem ich kreatywnego rozwinięcia. Semestr dziesiąty jest kontynuacją pracy nad zestawem prac dyplomowych. Jego zakończeniem jest wystawa i obrona dyplomu.Wymagania wstępne
Osoba studencka na piątym roku może kontynuować poruszane wcześniej problemy artystyczne pod warunkiem ich kreatywnego rozwinięcia lub podjąć zupełnie nowy problem używając wiedzy zdobytej we wszystkich poprzednich latach edukacji artystycznej.
Formy prowadzenia zajęć
zajęcia prowadzone stacjonarnie
(X)
ćwiczenia
wykłady
seminaria
zajęcia praktyczne artystyczne
zajęcia praktyczne projektowe
samodzielna nauka pod kierunkiem nauczyciela
wizyty w instytucjach/przedsiębiorstwach
Kryteria oceny
(Opis kryteriów wraz ze wskazaniem maksymalnej ilości punktów, które student może uzyskać w ramach każdego z kryteriów)
ocena cel. (5,5)
91–100 pkt – znakomita wiedza, umiejętności i kompetencje społeczne
ocena bdb (5)
81–90 pkt – bardzo dobra wiedza, umiejętności i kompetencje społeczne
ocena db+ (4,5)
71–80 pkt – więcej niż dobra wiedza, umiejętności i kompetencje społeczne
ocena db (4)
61–70 pkt – dobra wiedza, umiejętności i kompetencje społeczne
ocena dst+ (3,5)
51–60 pkt – więcej niż zadowalająca wiedza, umiejętności
i kompetencje społeczneocena 3
41–50 pkt – zadowalająca wiedza, umiejętności i kompetencje społeczne
ocena 2
31–40 pkt – niezadowalająca wiedza, umiejętności i kompetencje społeczne